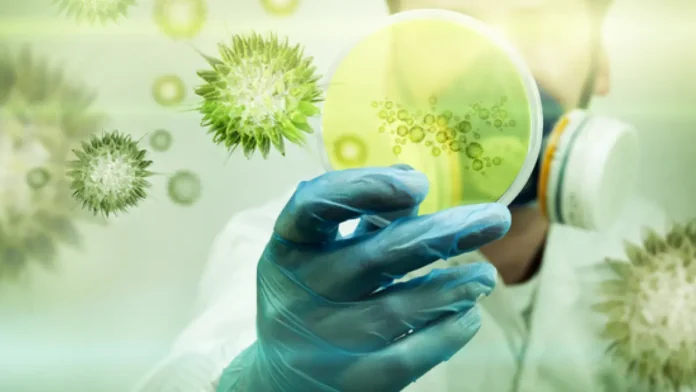
biorremediacao-4 Biorremediação

Ouro Núcleo Terra
Imagine por um momento que abaixo dos seus pés existe um tesouro tão imenso que poderia cobrir todo o planeta em uma camada dourada. Parece ficção científica, não é mesmo? Pois bem, essa realidade extraordinária acaba de ser revelada por uma descoberta científica que está revolucionando nossa compreensão sobre as riquezas ocultas do nosso planeta.
Uma pesquisa conduzida por cientistas da Universidade de Göttingen, na Alemanha, publicada na prestigiosa revista Nature em maio de 2025, trouxe uma revelação surpreendente: o ouro e outros metais preciosos estão literalmente “vazando” do núcleo da Terra e subindo em direção à superfície. Esta descoberta não apenas desafia nossa compreensão sobre a estrutura terrestre, mas também abre possibilidades fascinantes sobre o futuro da mineração e disponibilidade de metais preciosos.
O Maior Cofre do Mundo Fica a 3 Mil Quilômetros Abaixo de Nós
Para compreender a magnitude dessa descoberta, precisamos primeiro entender onde está localizada a maior reserva de ouro do planeta. Mais de 99% do ouro existente no mundo está enterrado a quase 3 mil quilômetros de profundidade, onde as temperaturas superam os 5.000°C. Essa profundidade colossal representa uma região totalmente inacessível para a tecnologia humana atual.
Mais de 99,999% das reservas de ouro e outros metais preciosos da Terra estão enterrados sob 3000 km de rocha sólida, fechados no núcleo metálico da Terra. Para ter uma perspectiva dessa dimensão, imagine que você pudesse cavar um túnel direto através do planeta – mesmo assim, não chegaria nem na metade do caminho até essas reservas douradas.
O núcleo terrestre funciona como uma verdadeira fortaleza de metais preciosos, onde condições extremas de temperatura e pressão mantêm esses elementos em um estado que, até recentemente, acreditávamos ser completamente isolado da superfície.
A Descoberta que Mudou Tudo: Vestígios de Ouro nas Ilhas Havaianas
A revolucionária descoberta aconteceu quando os pesquisadores estavam analisando rochas vulcânicas das Ilhas Havaianas. O que encontraram foi absolutamente extraordinário: traços de ouro e outros metais preciosos, como o rutênio, em rochas vulcânicas que devem ter vindo originalmente do núcleo da Terra.
O geoquímico Nils Messling, da Universidade de Göttingen, expressou sua surpresa com os resultados: “Quando os primeiros resultados chegaram, percebemos que tínhamos literalmente encontrado ouro. Nossos dados confirmaram que material do núcleo, incluindo ouro e outros metais preciosos, está vazando para o manto terrestre”.
Esta descoberta é particularmente significativa porque desafia a antiga crença de que o núcleo da Terra era completamente isolado das camadas superiores. A presença desses metais preciosos em rochas vulcânicas sugere que existe um processo natural de migração dessas substâncias das profundezas até áreas mais próximas da superfície.
Como Funciona o Processo de “Vazamento” do Ouro

O mecanismo por trás desse fenômeno fascinante está relacionado aos movimentos internos do nosso planeta. Este processo é facilitado pelo movimento do magma, que transporta esses elementos até a superfície. É como se a Terra tivesse um sistema circulatório interno que, ao longo de milhões de anos, transporta gradualmente esses tesouros ocultos.
As rochas vulcânicas atuam como mensageiros dessas profundezas extremas, carregando consigo evidências de um mundo subterrâneo rico em metais preciosos. Cada erupção vulcânica pode representar uma pequena “entrega” desses materiais valiosos do interior da Terra.
O processo não acontece de forma rápida ou dramática – estamos falando de um fenômeno geológico que ocorre ao longo de escalas de tempo imensas. No entanto, sua importância científica e econômica é inquestionável.
Implicações Revolucionárias para a Mineração e Tecnologia
Esta descoberta tem ramificações profundas para diversos setores da economia mundial. A migração de materiais do núcleo para o manto e, eventualmente, para a superfície, pode significar que parte dos suprimentos de ouro e outros metais preciosos, dos quais dependemos em setores como energia renovável, pode ter origem no núcleo da Terra.
Para a mineração de ouro, isso representa uma mudança de paradigma. Se conseguirmos compreender melhor os padrões de migração desses metais, poderemos identificar novas regiões promissoras para exploração. As áreas vulcanicamente ativas podem se tornar alvos prioritários para futura prospecção.
A indústria tecnológica também pode se beneficiar enormemente dessa descoberta. Metais como ouro, platina e rutênio são essenciais para componentes eletrônicos, células solares e outras tecnologias verdes. Uma melhor compreensão de sua distribuição natural pode otimizar os processos de extração e tornar essas tecnologias mais acessíveis.
O Futuro da Exploração de Metais Preciosos
A nova descoberta reforça a ideia de que parte desse tesouro está lentamente subindo, ajudando a formar regiões ricas em metais preciosos. Isso sugere que a distribuição de metais preciosos na crosta terrestre não é estática, mas sim um processo dinâmico e contínuo.
Os cientistas agora estão trabalhando para mapear esses fluxos de materiais e entender melhor os padrões de migração. Esta pesquisa pode levar ao desenvolvimento de novas técnicas de prospecção que levem em conta a origem profunda desses materiais.
A descoberta também levanta questões fascinantes sobre outros planetas e corpos celestes. Se processos similares ocorrem em outros mundos, isso pode influenciar futuras missões de exploração espacial e mineração extraterrestre.
Principais Pontos da Descoberta
• Localização: Mais de 99% do ouro mundial está a 3 mil km de profundidade no núcleo terrestre • Descoberta: Traços de ouro e rutênio encontrados em rochas vulcânicas havaianas • Processo: Movimento do magma transporta metais preciosos do núcleo à superfície
• Implicação: Mudança na compreensão sobre distribuição de metais preciosos • Futuro: Novas possibilidades para mineração e tecnologia verde
Uma Nova Era na Compreensão Terrestre

Esta descoberta marca o início de uma nova era na geologia e ciências da Terra. A compreensão de que nosso planeta possui um sistema ativo de circulação de metais preciosos das profundezas até a superfície abre possibilidades científicas e econômicas antes inimagináveis.
Para nós, habitantes da superfície, isso significa que o solo sob nossos pés está constantemente sendo enriquecido por tesouros vindos das profundezas mais extremas do planeta. É uma lembrança poderosa de que a Terra é um sistema dinâmico e complexo, cheio de segredos ainda por descobrir.
A pesquisa continuará expandindo nossa compreensão sobre esses processos, e é possível que futuras descobertas revelem ainda mais segredos sobre os tesouros ocultos do nosso planeta. O ouro que um dia pode adornar nossas joias ou compor nossos dispositivos eletrônicos pode muito bem ter iniciado sua jornada no coração ardente da Terra, milhões de anos atrás.
Perguntas Frequentes (FAQ’s)
1. Quanto ouro existe no núcleo da Terra?
O núcleo da Terra abriga mais de 99% de todo o ouro existente no planeta, localizado a aproximadamente 3 mil quilômetros de profundidade, onde as temperaturas superam 5.000°C.
2. É possível minerar o ouro que está vazando do núcleo?
Atualmente, a mineração direta do núcleo é impossível devido à profundidade e condições extremas. No entanto, o ouro que migra naturalmente através de processos vulcânicos pode se tornar acessível em regiões próximas à superfície.
3. Essa descoberta pode afetar o preço do ouro no mercado?
Embora a descoberta seja significativa cientificamente, o processo de migração do ouro ocorre em escalas de tempo geológicas muito longas, não afetando imediatamente a disponibilidade ou preços do mercado atual.
Fontes:
- Principal: www.globo.com